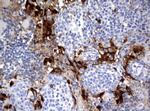
IDO1 Antibody in Immunohistochemistry (Paraffin) (IHC (P))

Search
OriGene
IDO1 Monoclonal Antibody (UMAB126), UltraMAB™
{{$productOrderCtrl.translations['antibody.pdp.commerceCard.promotion.promotions']}}
{{$productOrderCtrl.translations['antibody.pdp.commerceCard.promotion.viewpromo']}}
{{$productOrderCtrl.translations['antibody.pdp.commerceCard.promotion.promocode']}}: {{promo.promoCode}} {{promo.promoTitle}} {{promo.promoDescription}}. {{$productOrderCtrl.translations['antibody.pdp.commerceCard.promotion.learnmore']}}
产品信息
UM500091
种属反应
宿主/亚型
分类
类型
克隆号
抗原
偶联物
形式
浓度
纯化类型
保存液
内含物
保存条件
运输条件
靶标信息
IDO1 is an intracellular heme-containing enzyme that catalyzes the oxidative cleavage of the indole ring of several important regulatory molecules like tryptophan, serotonin, and melatonin. By doing this, IDO1 initiates the production of biologically active metabolites, commonly referred to as kynurenines. IDO1 is widely expressed in a variety of human tissues as well as in macrophages and dendritic cells (DCs). In inflammation, interferons (IFNs) act on specific receptors to trigger IDO1 induction. The production of IFN-gamma and induction of IDO1 represent important antimicrobial mechanisms. Degradation and depletion of tryptophan by IDO1 inhibits the growth of viruses, bacteria and parasites. Furthermore, IDO1 plays a complex and crucial role in immunoregulation during infection, pregnancy, autoimmunity, transplantation, and neoplasia.
仅用于科研。不用于诊断过程。未经明确授权不得转售。
生物信息学
蛋白别名: EC 1.13.11.52; IDO-1; indolamine 2,3 dioxygenase; indole 2,3-dioxygenase; indoleamine; Indoleamine 2,3-dioxygenase 1; Indoleamine-2; Indoleamine-pyrrole 2,3-dioxygenase
基因别名: IDO; IDO-1; IDO1; INDO
UniProt ID: (Human) P14902
Entrez Gene ID: (Human) 3620